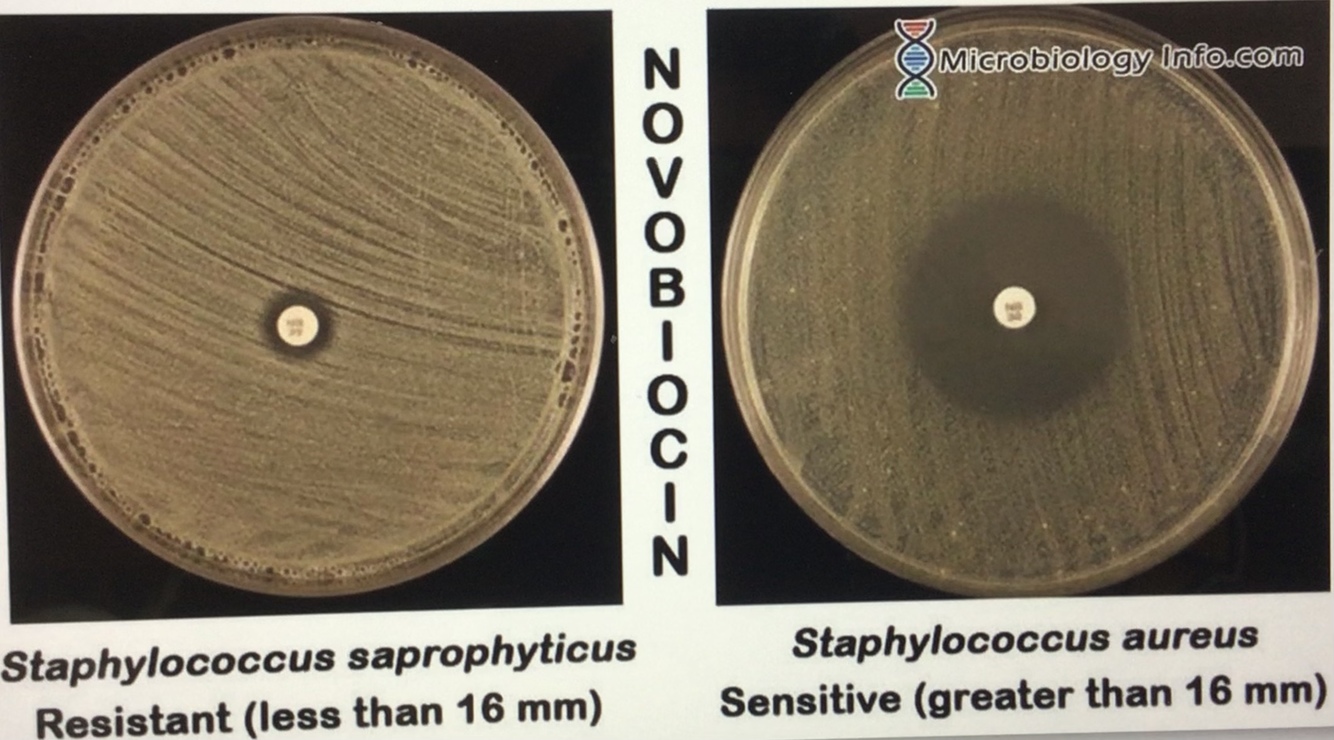
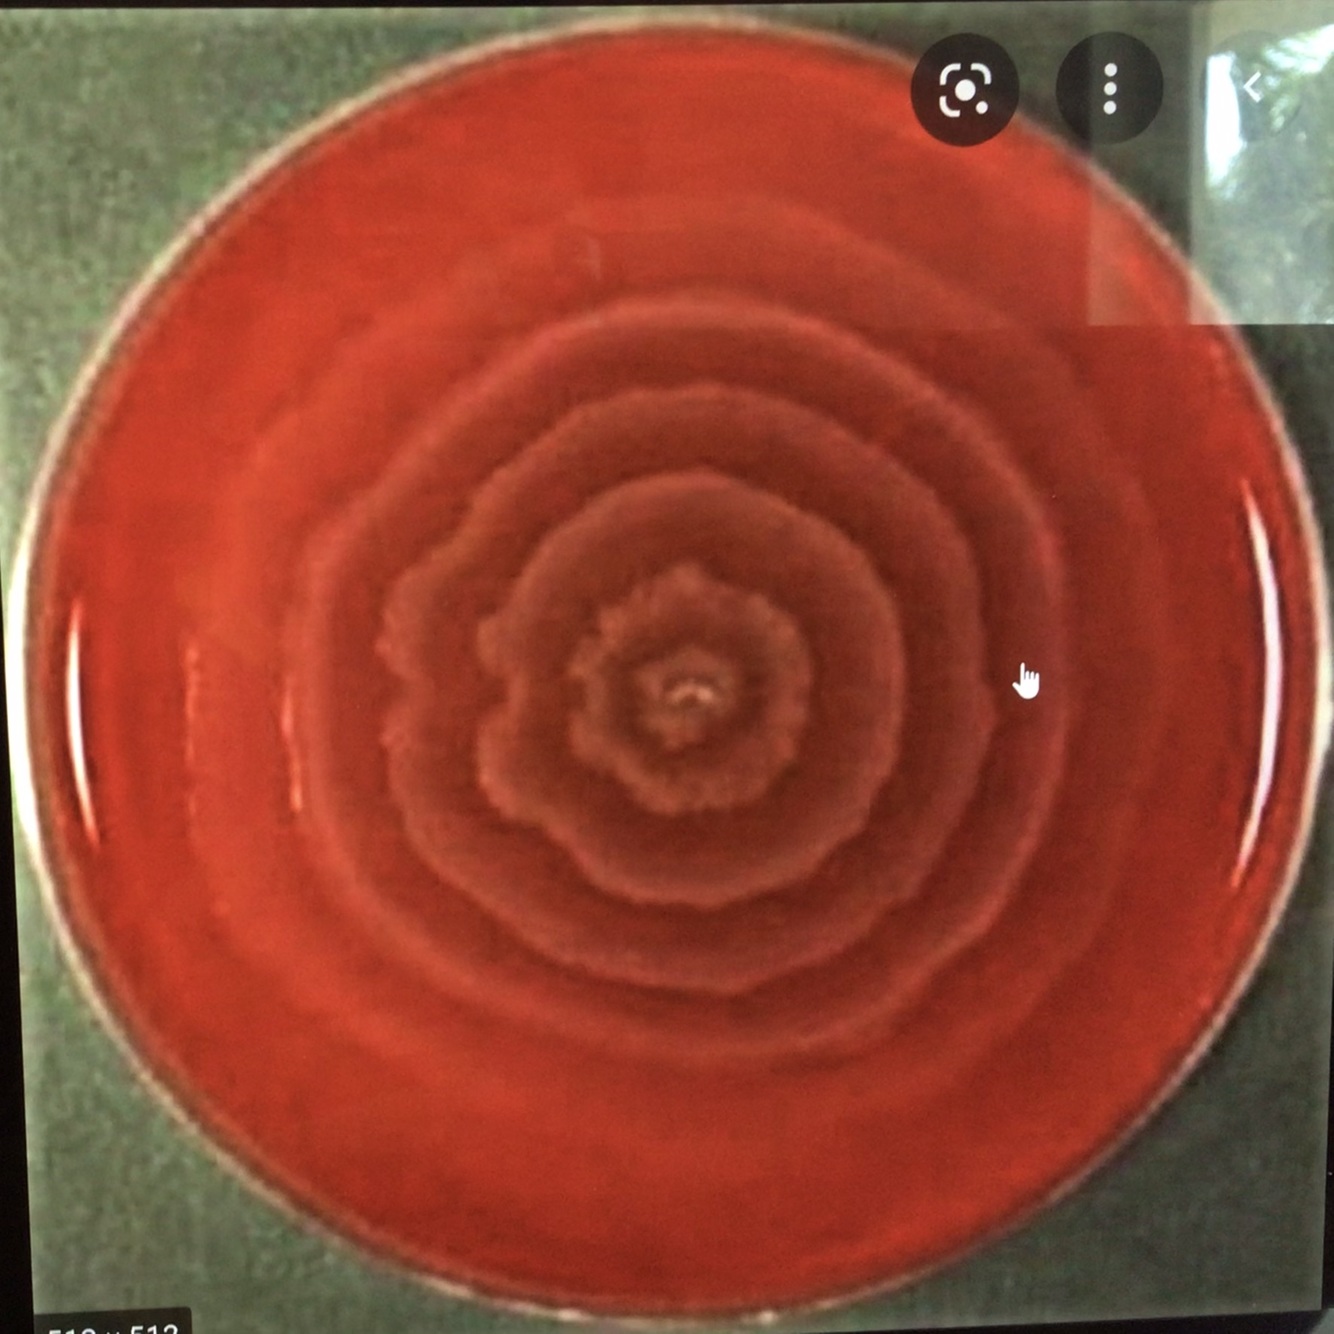

E. COLI characteristics
GRAM - Bacilli, Lactose Fermentator (Beta-Galactose), Encapsulated, motile (explains Asc UTI’S), UREASE -
Where E.coli Grows
-Eosin Methylene Blue agar (black colonies)
-MaConkey
What bacteria Grows in Eosin methylene Blue agar
E.coli
E.Coli virulence Factors ass. (3)
**Fimbria **(cystitis and Pyelonephritis)
K capsule (meningitis and pneumonia)
LPS Endotoxin (septic shock)
Thrombocytopenia, Hemolytic anemia, Azotemia ass with Hamburger eating 1 day ago. .
STEC (Shiga Like Toxin producing E.coli). = Entero-Hemorargic E.coli (EHEC)
Schistocytes….
Why female get UTI more common
Shorter urethra+ closer to anal canal.
STECT (E.coli) special characteristic
DOSENT fermented SORBITOL
0157:H7
EHEC ,ass HUS E.coli
How do you differentiated between Staph Saprophyticus and Epidermais
Saprophytycus is NovoBiocin resistant (or negative sensative).
Travelers diahrrhea ass with?
-Entero-Toxigenic E.Coli
-Heat labile and Heat stable Enterotoxin–>inflamation of intestine–>**Watery diarrhea. **
Entero-Pathogenic E.Coli (EPEC)
-<2yr old, NO toxin produced-->causes Intestinal epi flattening by going intracellular and damaging cytoskeleton–>DECR absorption water and nutrients–>watery diarrhea.
Uropathogenic E.Coli (UPEC) virulence factors
-P Fimbriae-->helps in ascending throught kidney
-Type 1 Pilli–>helps in attachement on epitheleal cells.
-alpha and Beta Hemolysin–>lysis of cells in urinary tract.
What serotype ?
Dysuria,Incr urinary frequence and flank pain//On culture you see GRMA- bacilli with motile and is encapsulated.
Uropathogenic-E.Coli (UPEC)
Describe
-Image on right shows sensitivity towards novobiocin (Stap. Aureus and Epidermadis)
-Image on left has resistance.
-This test used to differentiate between staphyloccocus organisms.
-GRAM+ in clusters,coagulase -, Novobiocin resistant,urease +
-Ass sexually active female in her 20’s…
-Staph Saprophyticus.
Common risk factor for all microbes that are UREASE+.
-Urease + converts urea–>ammonia + CO2—>INCR pH (alkalanization)–>promotes formation of struvite stones (made up off ammonia+phosphate+magnesium)
Klebsiella,Staph. saprophyticus, Proteus mirabilis have in common?
-All are urease +.
-Priamary cause of UTI in females?
-Secondary
-E.COLI
-Staph saprophyticus.
Lactose fermentador and NOT urease +

E.coli
DIAGNOSIS and caharacteristics
-Proteus Mirabilis (Ripple=SWARMING)
-GRAM- Bacilli,urease+,aggresivly motile,POLYMORPHIC Hydrogen sulfate** NON-LACTOSE FERMENTADOR**–>differentiate between E.Coli.
-Ass with old people Hospitalized with catheter placement.
What microbes are polymorphic?
Proteus mirabilis and H.Influenza.
DIAGNOSIS
-Exposure to catheter forms “swarm cells” (100-1k flagella–>aggressive motile)–>moves along catheter until reaches epi.–>use Fimbriea to attach–>rel. Hemolysin.
Proteus Mirabilis
Triple Sugar Iron Test used for what?
-Used for diagnosis of Proteus mirabilis–>has Hydrogen Sulfate.
Fishy odor?
-Proteus Mirabilis.








